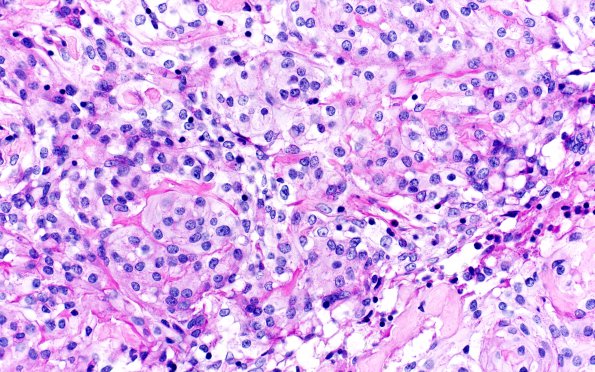
20C3 Clear cell meningioma (Case 20) PAS 40X 2

Table of Contents
Washington University Experience | NEOPLASMS (MENINGIOMA) | Meningioma - Clear cell | 20C3 Clear cell meningioma (Case 20) PAS 40X 2
PAS staining in clear cell meningioma may be subtle, as in this case, but comparison demonstrates a diastase effect.